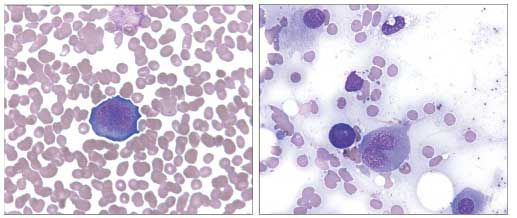

- Clinical Technology
- Adult Immunization
- Hepatology
- Pediatric Immunization
- Screening
- Psychiatry
- Allergy
- Women's Health
- Cardiology
- Pediatrics
- Dermatology
- Endocrinology
- Pain Management
- Gastroenterology
- Infectious Disease
- Obesity Medicine
- Rheumatology
- Nephrology
- Neurology
- Pulmonology
Unsuspected Parvovirus B19 Infection in a Person With AIDS
Persons with HIV infection frequently present with anemia from different causes, including use of antiretroviral therapy (typically zidovudine), iron deficiency, vitamin B12 deficiency, opportunistic infections (such as mycobacterial and fungal infections), chronic disease, AIDS-associated malignancies, autoimmune hemolysis, and direct effects of HIV infection itself. A frequently overlooked cause of chronic anemia in HIV-infected persons is parvovirus B19 coinfection.1-3 We present an illustrative case of unsuspected treatable parvovirus B19 infection in an HIV-positive person with chronic transfusion-dependent anemia initially attributed solely to zidovudine therapy.
Persons with HIV infection frequently present with anemia from different causes, including use of antiretroviral therapy (typically zidovudine), iron deficiency, vitamin B12 deficiency, opportunistic infections (such as mycobacterial and fungal infections), chronic disease, AIDS-associated malignancies, autoimmune hemolysis, and direct effects of HIV infection itself. A frequently overlooked cause of chronic anemia in HIV-infected persons is parvovirus B19 coinfection.1-3 We present an illustrative case of unsuspected treatable parvovirus B19 infection in an HIV-positive person with chronic transfusion-dependent anemia initially attributed solely to zidovudine therapy.
A 35-year-old homosexual man with a known diagnosis of AIDS for 5 years presented with increasing dyspnea, fever, and pleuritic chest pain of 3 days’ duration. His medical history was significant for Pneumocystis jiroveci pneumonia and Mycobacterium avium-intracellulare bacteremia. His antiretroviral drug regimen included zidovudine. He also had chronic symptomatic anemia, which was attributed to zidovudine. He received a total of 53 units of red blood cell transfusions over an 18-month period.
Physical examination findings were remarkable for left pulmonary basilar rales and rhonchi, slight muscle wasting, oral thrush, and hyperesthesia of his feet bilaterally with decreased sensation to light touch on the tops of his feet. The results of pertinent laboratory tests were as follows: white blood cell count, 2200/µL; hematocrit, 23%; hemoglobin, 8.7 g/dL; mean corpuscular volume, 87 fL; platelet count, 341,000/µL. The white blood cell differential showed 1% bands and an absolute neutrophil count of 483/µL. His reticulocyte count was 0.4% (normal, 0.5% to 1.5%). His CD4+ cell count was 9/µL, and an HIV RNA measurement was not available at this time.
Figure 1.Bone marrow aspirate smears showing giant pronormoblasts characteristic of parvovirus infection (Giemsa stain, oil immersion, original magnification ×1000).
A chest radiograph and subsequent CT scan demonstrated a 4.8 × 4.8-cm homogeneous, well-demarcated mass in his left lower lung lobe. Results of the evaluation of a biopsy specimen from this mass showed diffuse large B-cell lymphoma. A bone marrow biopsy for staging purposes was negative for lymphoma. However, pure red cell aplasia with giant pronormoblasts (Figure 1) and viral inclusions (Figure 2) consistent with parvovirus infection were identified. Serological assays detected parvovirus B19 IgM and IgG antibodies. The presence of parvovirus DNA in the patient’s serum was confirmed by polymerase chain reaction (PCR) amplification. While parvovirus infection may not be the sole cause of this person’s anemia, this may explain the acute exacerbation of his anemia near the time of his bone marrow procedure.

Figure 2.Bone marrow core biopsy specimen showing parvovirus intranuclear inclusions (arrows) within erythroid elements (hematoxylin and eosin stain, oil immersion, original magnification ×1000). View at right has been enlarged.
The patient received chemotherapy for his lymphoma, which consisted of cyclophosphamide, doxorubicin, vincristine, and prednisone. A 5-day course of intravenous immunoglobulin (IVIG) was also given to treat his parvovirus B19 infection. He had a complete clinical recovery from his anemia in 2 weeks. However, 6 months later he relapsed with persistent fevers and anemia. He died before any laboratory tests could be performed.
Human parvovirus B19 is a small, single-stranded, nonenveloped DNA virus that replicates in human erythroid precursors, inhibiting erythropoiesis and thereby resulting in decreased red cell production and anemia. This unique tropism is related to the presence of the P blood group antigen, which is found in high concentrations on cells of erythroid lineage. In addition, the coreceptors α5β1-integrin and Ku80 also play a role in parvovirus B19 infection.4 Immunocompromised persons are unable to mount a neutralizing antibody response against parvovirus B19 and, hence, are unable to clear this virus. This causes persistent bone marrow insufficiency that manifests as pure red cell aplasia and chronic anemia. This chronic anemia is characterized by reticulocytopenia and a normocytic anemia.
Although the erythroid lineage is most affected, thrombocytopenia and neutropenia (ie, pancytopenia) have also been described.3,5 An association with hemophagocytic syndrome has also been reported.6 Respiratory transmission is the most common way one acquires this virus. Hematogenous transmission can also occur via the administration of infected blood products.
The presence of giant pronormoblasts with finely granulated cytoplasm and glassy, eosinophilic, intranuclear inclusions that show a clear halo in bone marrow biopsy samples is highly suggestive of parvovirus B19 infection.7 In a person with a large-cell lymphoma, lymphoma cells would need to be included in the morphological differential diagnosis for large cells identified in an aspirate smear.
In immunocompetent persons, the preferred method of diagnosis is serological testing to detect circulating parvovirus B19–specific IgM and IgG antibodies. IgM levels can be measured within 7 to 10 days of virus exposure and remain elevated for several months before diminishing. The positivity for IgM in this case raises the possibility that this is a more recent infection. In immunosuppressed persons, nucleic acid amplification testing (NAAT) is recommended, by isolation of viral DNA with direct hybridization or PCR assay. Appropriate clinical specimens for NAAT analysis include serum, plasma, and bone marrow. Immunohistochemical studies using parvovirus B19–specific antibodies, with approximately 80% sensitivity, are also useful for rapid confirmation. Glycophorin or hemoglobin immunostain can show whether the cells with inclusions are of erythroid origin. In situ hybridization is more sensitive than immunohistochemistry in parvovirus B19 detection in formalin-fixed, paraffin-embedded bone marrow biopsies; therefore, it’s use is preferred if it is available.8
The diagnosis of parvovirus B19 infection is established when the following criteria are met: a bone marrow biopsy sample shows pure red cell aplasia or hypoplasia with giant pronormoblasts and intranuclear inclusions; there is serum IgM positivity and/or bone marrow positivity for parvovirus B19 DNA; and no alternative explanation for anemia can be demonstrated.9 In a person whose anemia has many potential explanations, such as the patient presented here, it may be difficult to fulfill the last of these diagnostic criteria.
A person with parvovirus B19 infection who has mild anemia or who is asymptomatic does not require treatment. In some cases, however, when parvovirus B19 infection is associated with sufficiently severe complications, treatment is indicated and may even be lifesaving. The treatment for a transient aplastic crisis is blood transfusion to prevent congestive heart failure.
The correct management of chronic pure red cell aplasia caused by parvovirus B19 in persons with HIV/AIDS is unclear. Several IVIG regimens have been used with good results in these immunocompromised persons suffering from chronic anemia.10,11 In one person with AIDS, erythropoietin treatment exacerbated his parvovirus coinfection.12 An alternative explanation for anemia must be sought in those patients who do not respond to IVIG. Persons with CD4+ T-cell counts under 80/µL may relapse within 6 months, necessitating re-treatment with IVIG. A maintenance dose may be required to prevent relapse.13 Recently, treatment with highly active antiretroviral therapy has been reported to result in complete remission for persistent parvovirus B19 infection in persons with HIV/AIDS.14-17 However, clinicians need to be aware that parvovirus B19 may trigger an immune reconstitution inflammatory syndrome in HIV-infected persons who are beginning antiretroviral therapy.18
References:
References1. Koduri PR. Parvovirus B19-related anemia in HIV-infected patients. AIDS Patient Care STDS. 2000;14:7-11.
2. Frickhofen N, Abkowitz JL, Safford M, et al. Persistent B19 parvovirus infection in patients infected with human immunodeficiency virus type 1 (HIV-1): a treatable cause of anemia in AIDS. Ann Intern Med. 1990;113:926-933.
3. Florea AV, Ionescu DN, Melhem MF. Parvovirus B19 infection in the immunocompromised host. Arch Pathol Lab Med. 2007;131:799-804.
4. Weigel-Kelley KA, Yoder MC, Srivastava A. Alpha5beta1 integrin as a cellular coreceptor for human parvovirus B19: requirement of functional activation of beta1 integrin for viral entry. Blood. 2003;102:3927-3933.
5. Alliot C, Barrios M, Taib J, Brunel M. Parovirus B19 infection in an HIV-infected patient with febrile pancytopenia and acute hepatitis. Eur J Clin Microbiol Infect Dis. 2001;20:43-45.
6. Yilmaz S, Oren H, Demircioglu F, et al. Parvovirus B19: a cause for aplastic crisis and hemophagocytic lymphohistiocytosis. Pediatr Blood Cancer. 2006;47:861.
7. Crook TW, Rogers BB, McFarland RD, et al. Unusual bone marrow manifestations of parvovirus B19 infection in immunocompromised patients. Hum Pathol. 2000;31:161-168.
8. Liu W, Ittmann M, Liu J, et al. Human parvovirus B19 in bone marrows from adults with acquired immunodeficiency syndrome: a comparative study using in situ hybridization and immunohistochemistry. Hum Pathol. 1997;28:760-766.
9. Heegaard ED, Brown KE. Human parvovirus B19. Clin Microbiol Rev. 2002;15:485-505.
10. Koduri PR, Kumapley R, Valladares J, Teter C. Chronic pure red cell aplasia caused by parvovirus B19 in AIDS: use of intravenous immunoglobulin-a report of eight patients. Am J Hematol. 1999;61:16-20.
11. Kurtzman G, Frickhofen N, Kimball J, et al. Pure red-cell aplasia of 10 years’ duration due to persistent parvovirus B19 infection and its cure with immunoglobulin therapy. N Engl J Med. 1989;321:519-523.
12. Borkowski J, Amrikachi M, Hudnall SD. Fulminant parvovirus infection following erythropoietin treatment in a patient with acquired immunodeficiency syndrome. Arch Pathol Lab Med. 2000;124:441-445.
13. Ramratnam B, Gollerkeri A, Schiffman FJ, et al. Management of persistent B19 parvovirus infection in AIDS. Br J Haematol. 1995;91:90-92.
14. Mylonakis E, Dickinson BP, Mileno MD, et al. Persistent parvovirus B19 related anemia of seven years’ duration in an HIV-infected patient: complete remission associated with highly active antiretroviral therapy. Am J Hematol. 1999;60:164-166.
15. Scapellato PG, Palumbo AM, Del Valle S. Improvement of anemia induced by parvovirus B19 in a patient with AIDS after combined antiretroviral therapy. Mayo Clin Proc. 2000;75:215-216.
16. Chen MY, Hung CC, Fang CT, Hsieh SM. Reconstituted immunity against persistent parvovirus B19 infection in a patient with acquired immunodeficiency syndrome after highly active antiretroviral therapy. Clin Infect Dis. 2001;32:1361-1365.
17. Ware AJ, Moore T. Resolution of chronic parvovirus b19-induced anemia, by use of highly active antiretroviral therapy, in a patient with acquired immunodeficiency syndrome. Clin Infect Dis. 2001;32:E122-E123.
18. Intalapaporn P, Poovorawan Y, Suankratay C. Immune reconstitution syndrome associated with parvovirus B19-induced pure red cell aplasia during highly active antiretroviral therapy. J Infect. 2006;53:e79-e82.
